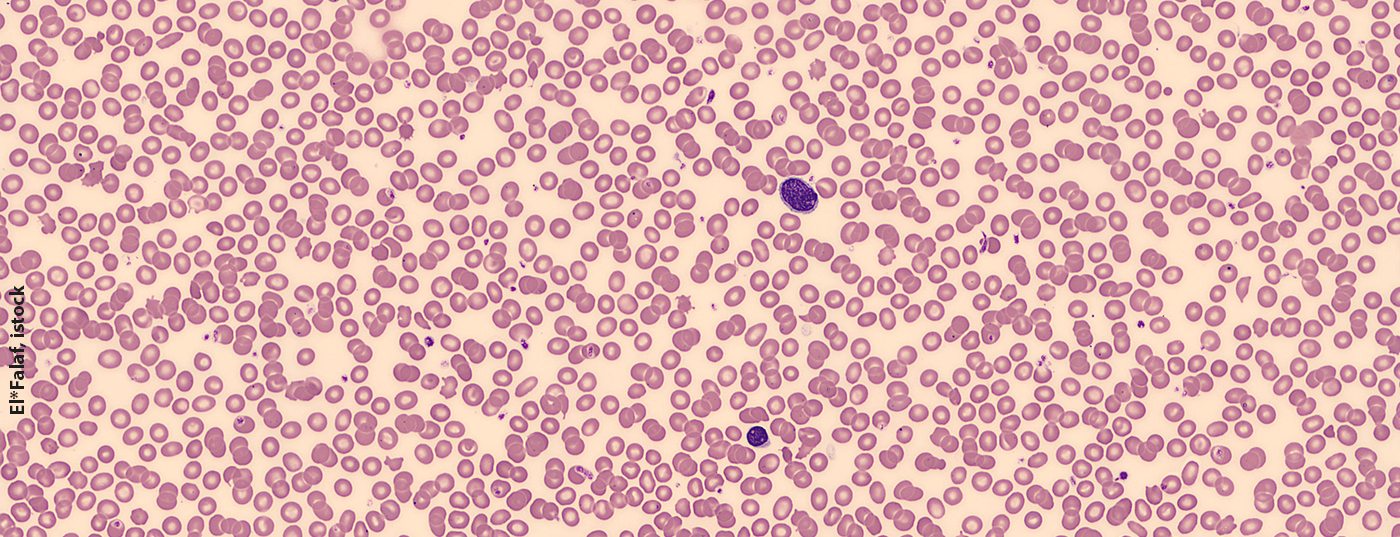
sezary_wikimedia

Mit fortschreitender Erkrankung breiten sich die Tumorzellen bei leukämischen Varianten kutaner T-Zell-Lymphome nicht nur in der Haut, sondern auch im Blut und in Lymphknoten aus. Obschon eine steigende Anzahl umfangreicher Sequenzierungsstudien auf genetische Abweichungen hinweist, sind die Treibermutationen bisher nicht bekannt. Eine neue Studie hat STAT5 als mögliches therapeutisches Target identifiziert.